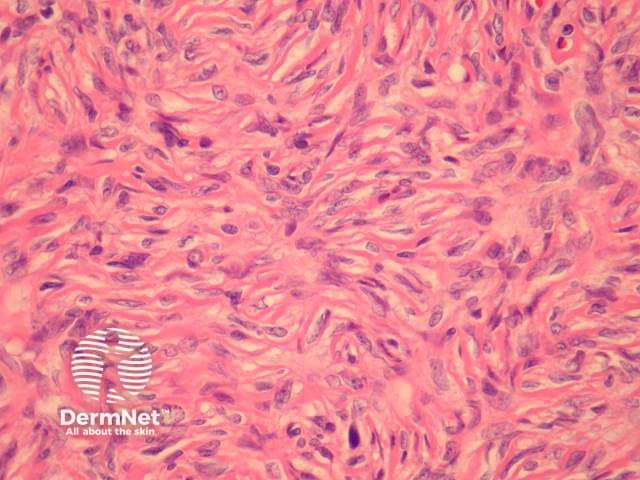
Figure 4
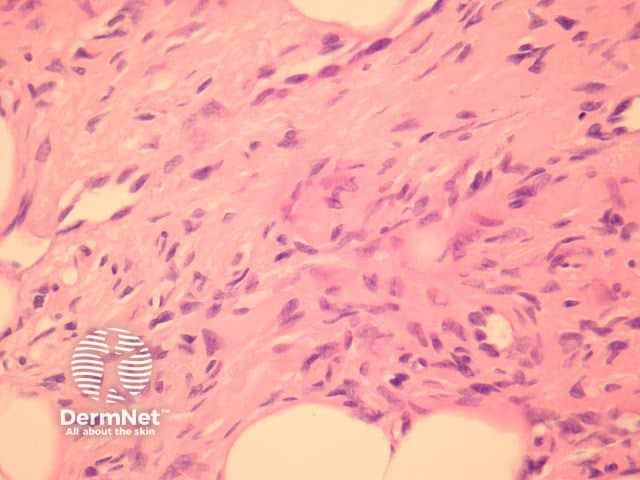
Figure 5
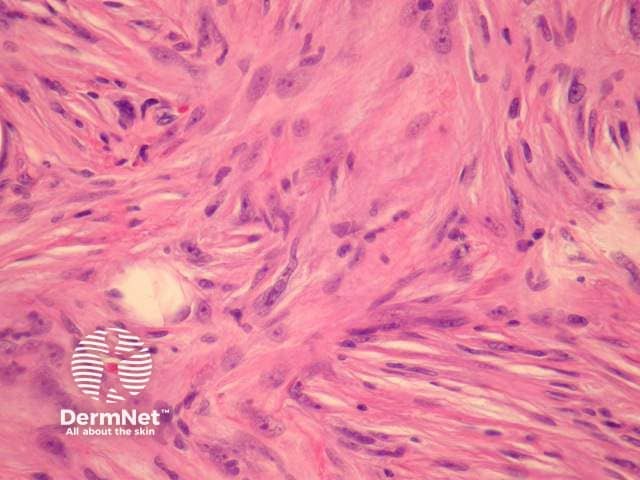
Figure 6

Main menu
Common skin conditions

NEWS
Join DermNet PRO
Read more
Quick links
Lesions (cancerous) Diagnosis and testing
Author: Dr Harriet Cheng, Dermatology Registrar, Waikato Hospital, Hamilton, New Zealand, 2013.
Introduction
Histology
Special studies
Differential diagnoses
Dermatofibrosarcoma protuberans (DFSP) is a locally aggressive tumour of fibroblastic origin. The initial lesion is a skin-coloured plaque which develops a red/brown colour and nodular surface.
Dermatofibrosarcoma protuberans consists of a proliferation of spindle-shaped cells in the deep dermis with later lesions infiltrating the subcutaneous fat (Figures 1, 2). Invasion of muscle may occur. There is often superficial sparing, however, the involvement of the epidermis and ulceration is sometimes seen. Spindled tumour cells are quite uniform in appearance with elongated nuclei and little or no pleomorphism (Figures 3-5) and may be arranged in a storiform manner (swirled and interwoven, figure 6).

Figure 1

Figure 2

Figure 3
Figure 4
Figure 5
Figure 6

Figure 7
Characteristic positivity for CD34 (Figure 7). Negative CD31 and smooth muscle actin.
Cellular dermatofibroma — a radial proliferation of cells with large nuclei. May have haemosiderin deposits. Central part negative for CD34, positive for Factor XIIIa.
Dermal sarcoma — marked nuclear polymorphism and frequent mitoses are differentiating features from dermatofibrosarcoma protuberans.
Leiomyosarcoma — pleomorphic spindle cell tumour with cigar-shaped nuclei and mitoses. Smooth muscle actin positive.
Desmoplastic melanoma — fibrosis and focal lymphocytic infiltrates are additional features. Tumour cells are S100 positive.
Neurofibroma — S100 positive spindle cell tumour. Mast cells may be present.
Fibrosarcomatous dermatofibrosarcoma protuberans — a variant of dermatofibrosarcoma protuberans representing tumour progression. A focal fascicular or 'herring-bone' pattern is present. More cellular than usual dermatofibrosarcoma protuberans with increased nuclear pleomorphism and mitotic figure count. Staining for CD34 is reduced.